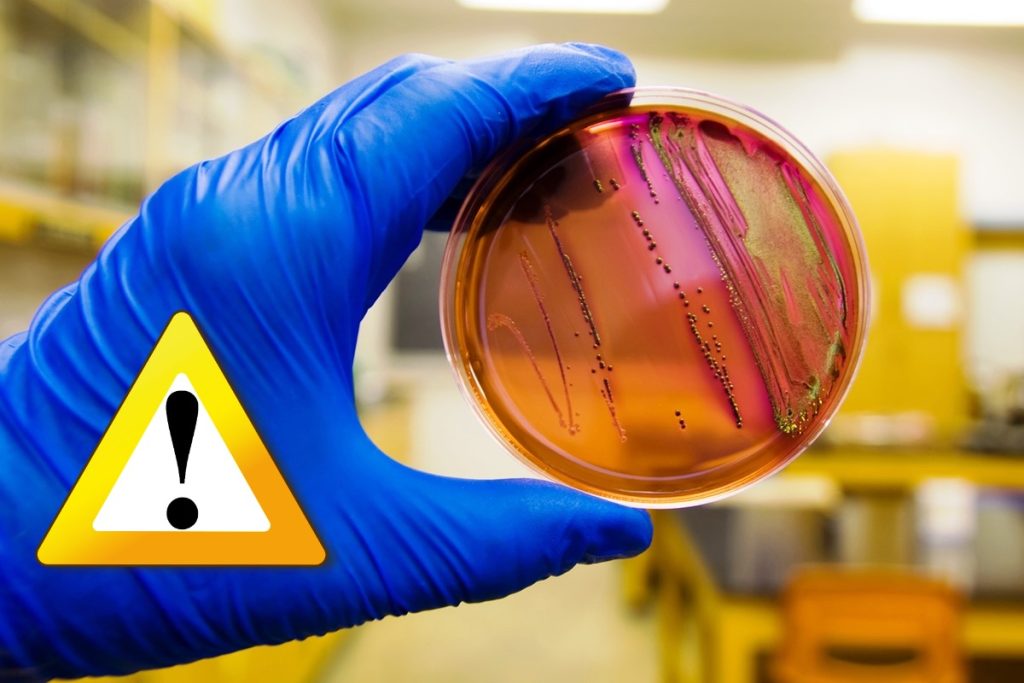
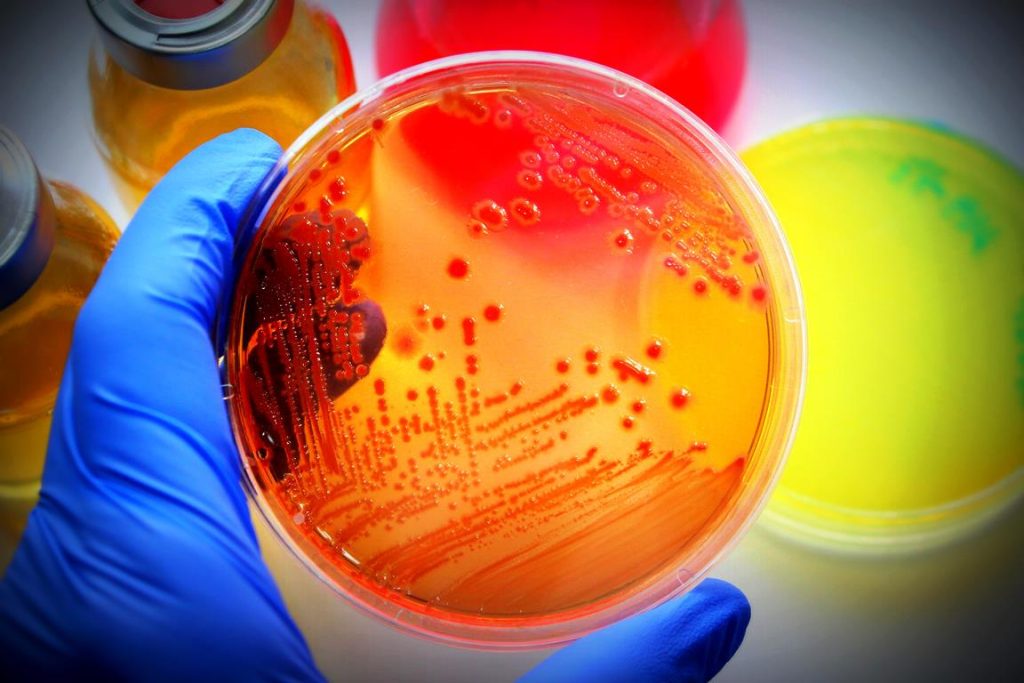

Un austriac aflat în concediu în România: În vara lui 2022, la Pârscov, o mică localitate aflată pe Valea Buzăului, la mai bine de 30 km de reședința de județ, m-am întâlnit probabil cu… Escherichia Coli, o bacterie coliformă de origine fecală. Pentru mine a fost o nefericită premieră. Să te speli e bine. Să te speli cu apă murdară însă, nu e bine.
Fără să știu, am spălat vasele cu apă din rețeaua urbană și m-am căptușit cu bacterii. Mi-au trebuit săptămâni bune de tratament. Disconfort și costuri.
Apa, contaminată cu bacterii e-coli, ar trebui sa fie fiartă inainte de a fi consumată. Nu am știut, nu am făcut. Spălatul pe dinti cu aceasta apa nu este recomandat. Eu m-am spălat pe dinți la Pârscov! Am pățit-o nasol și caut să aflu circumstanțele.
Citește șia. Fotbalist austriac, îngrozit de condițiile din România: ”Evit complet carnea, niciodată nu știi de unde provine”
Un austriac aflat în concediu în România
Cunosc la Pârscov oameni muncitori și prietenoși. Primitori cu străinii. Obișnuiți cu turiștii, poate și pentru că în zonă funcționează o serie de pensiuni cochete, mai tot timpul pline de oaspeți. Care poate au folosit și ei, ca și mine, apa de la robinet. Alarmat de ceea ce mi s-a întâmplat mie în vară, în concediu, i-am întrebat pe localnici despre calitatea apei.
Nu mică mi-a fost mirarea să aflu că la Pârscov s-au identificat în trecut bacterii coliforme în apa menajeră. Aouleu. Există în spațiul virtual imagini, filmate în vara anului 2022, care par să arate surse de contaminare ale apei, vezi AICI.
Reporterul de ocazie din Pârscov se întreabă retoric: „Tu ai bea această apă?“ Eu, Stan-Pățitul după ședera la Pârscov, îi răspund: Nu! Și înțeleg și că DSP-ul ar fi concluzionat scriptic deja în 2021: „au fost găsite bacterii coliforme“. Cauzele, tot felul de daravele, care au toate ceva în comun: contaminarea cu gunoi. Murdăria. În obște există un soi de gară care leagă Pârscovul chiar și direct până la București, printr-un tren al unui transportator privat, care se deplasează încet și legănat mai întâi către Buzău, pe un singur fir, precum acum mai bine de o sută de ani, atunci când comuna s-a așezat pe harta progresului.
Nu-i astfel de mirare că și apa poate face probleme.
Astăzi, peroanele sunt deteriorare și murdare, câinii vagabonzi mișună nestingheriți…, iar progresul ultimilor ani pare a se rezuma în ochii unora la asfaltarea preferențială a unor anumite ulițe din comună și achiziționarea unei noi mașini de pompieri, de mai bine de 30 de ani vechime. Locul în care în fiecare marți e zi de târg și astfel se strâng sute de oameni este un spațiu, numit gentil, insalubru.
Sătenii, producătorii agricoli, precupeții își etaleaza marfa pe pâmânt, atunci când ploua înoată în șleauri de noroi. De ani de zile, taman înainte de alegeri, se începe amenajarea acestui spațiu din buricul târgului, care apoi întârzie a se întâmpla. Până și mașina care ar trebui să strângă gunoiul la Pârscov nu prea funcționează. Gunoiul menajer rămâne cu săptămânile neridicat, deși serviciul comunal costă.
Nu-i astfel de mirare că și apa poate face probleme. Dintre care unii o au, venită prin țeava din bătătură, de culoare maronie, mirosind fatidic, după cum arată imaginile de pe fb și comentează localnicii. Unii mai susțin cum că ar fi chiar și o sursă de captare a apei prin preajma gării decrepite. Habar n-am dacă-i adevărat. Oare turiștii, care trec de „vulcanii noroioși”, mergând spre munte, să evite Pârscovul, localitatea care găzduiește totuși Casa memorială „Vasile Voiculescu”?
De ce autoritățile competente nu se înghesuie să controleze temeinic și regulat calitatea apei de la Pârscov, respectând metodologia de prelevare a probelor? Sau o fac și nu știu eu… Concediul meu, vacs. Sănătatea mea, vacs. Încrederea mea în calitatea apei de băut din Pârscov, vacs. Mai bine rămâneam împuțit. Mai mare rușinea.
(AT)
Postarea Un austriac aflat în concediu în România: ”M-am spălat pe dinți la Pârscov și m-am trezit infectat cu Escherichia Coli“ a apărut prima pe Ziarul Românesc Austria.
Sursa acestui editorial informativ în știri, este ziarulromanesc.at, știre pe care o preluăm.
Împotriva articolelor redacției noastre, persoanele nemulțumite pot formula Contestație în termen de 10 zile de la publicarea articolului, la judecătoria Orășenească nr. 1 München Bayern Deutschland, in conformitate cu Legea federală Germană. Considerăm că nu se pot formula acțiuni la instanțele din România deoarece nici o persoană care activează în trustul nostru nu poate fi extrasă de sub jurisdicția federală germană. Considerăm că redacția noastră nu răspunde în fața autorităților din România ci doar celor federale sau civile germane. deoarece legea română nu are efecte de extraneitate asupra redacției chiar dacă subiectul știrilor face obiectul unor evenimente sau persoane din România și sunt scrise în limba română. Limba română nu este izvor de extraneitate a legii.
